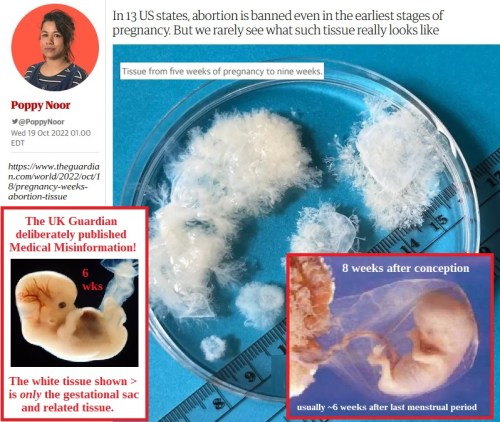

COVID-19: A new study confirms what we here already knew, which is that promoting Vitamin D supplementation and telling people to get outside in the sun would have saved lives.
A team of researchers from multiple institutions – including Johns Hopkins, the Universities of Michigan and Illinois, and the National Bureau of Economic Research – found that D2 reduced ‘rona infection by 28%, while D3 reduced it by 20%. Among those who caught the bug, D2 reduced mortality by 25%, while D3 reduced it 33%. The study noted that, although at least half of Americans are deficient in Vitamin D, supplementation is affordable, widely available, and safe in appropriate doses.
If you supplement, take your D with the meal that has the largest proportion of fat. This will greatly improve your body’s ability to absorb and utilize the vitamin. Also, keep an eye on your totals. D is among the fat soluble vitamins, meaning your body will store rather than excrete any excess. Long term hyper-supplementation can lead to toxicity and I’m noticing more blends are including D and some of the amounts are at or above the safety line.
You may want to ask your doctor to include Vitamin D in your annual blood work; despite widespread deficiency and the importance of this vitamin to your immune system, testing is not routinely done. The first time I asked for it, my primary warned that my insurance might not cover it. However, I never got a bill and he has included it ever since.
- https://www.lifesitenews.com/news/vitamin-d-associated-with-25-or-more-decreased-risk-of-covid-death-study-finds/
- https://ods.od.nih.gov/factsheets/Vitamind-HealthProfessional/#h2
- https://www.healthline.com/nutrition/best-time-to-take-vitamin-d
- https://www.healthline.com/nutrition/how-much-vitamin-d-is-too-much#TOC_TITLE_HDR_2

DETRANS: Camille Kiefel is the second ex-trannie I’ve heard about who is suing the people who shoved her into a double mastectomy. Her complaint says the defendants “abused their positions of professional trust and authority with intent to cause, or with reckless disregard.”

DISNEY: They spent $180 million making it. Its first five days in theaters brought in less than $24 million.

FAUCI: The Attorneys General for Louisiana and Missouri deposed St. Tony as part of their landmark lawsuit against the federal government for colluding with social media companies to censor speech. Prior to the deposition, Landry had said he hoped to find out how involved Fauci had been in censoring what we were allowed to know during the pandemic. Sadly, the man once hailed as “the most important, consequential public servant in the United States in the last half century” was unable to remember what the hell he did or did not do during the pandemic.
- https://notthebee.com/article/he-cant-recall-practically-anything-louisiana-ag-criticizes-fauci-for-not-answering-questions-during-deposition-about-his-handling-of-covid-19
- https://justthenews.com/politics-policy/coronavirus/louisiana-attorney-general-fauci-cant-recall-details-his-covid-19
- https://ijr.com/wh-officials-lavish-praise-fauci-important-public-servant/

GERMANY: The Federal Administrative Court in Leipzig has ruled that Bavaria’s restrictions on movement during the coronavirus crisis were “a serious interference with fundamental rights” and “not compatible with the principle of proportionality.”
LIFE: The UK Guardian is under fire for publishing deliberate misinformation about early fetal development in an obvious bid to promote abortion. The photo above is one of a series presented in the article. All of them were labeled as “pregnancy tissue” from various early stages of gestation. None of them included the fetus.
- https://www.theguardian.com/world/2022/oct/18/pregnancy-weeks-abortion-tissue
- https://www.lifesitenews.com/news/parents-of-miscarried-babies-slam-uk-newspaper-over-misleading-images-of-preborn-children/
- https://clinicquotes.com/pictures-of-unborn-babies-at-different-stages-of-development-in-the-first-trimester/

MEDIA: Following the deadly shooting at Club Q, the Left Stream rushed to cast the shooter as a right-winger who had been inflamed to hate by other right-wingers. Once the shooter’s identity as one of their own came out, the Left lost interest in the story.
CLICK https://rumble.com/v1wvwb2-they-are-cold-blooded-liars-tucker-slams-dishonest-medias-coverage-of-color.html [9:43] to hear Tucker’s report.
CLICK https://rumble.com/v1wvt6k-transgender-cnn-guest-says-you-can-tell-difference-between-men-and-woman-ba.html [:45] to hear a man pretending to be woman say the shooter can’t possibly be non-binary.
CLICK https://rumble.com/v1wokoo-cnn-anchor-speechless-as-she-reports-gay-club-shooter-is-non-binary.html [1:08] to hear CNN anchors claim the shooter is just preparing his defense.
Funny thing how they’re reacting, given their “how dare you question” attitude toward sex felons and mediocre male athletes who claim to be women. Why is it okay to question the shooter as “just preparing a defense” when those other two categories are just as likely to be faking it so they can be housed with preferred prey or win trophies and score scholarships?

MOSQUITOES: Scientists have modified male mosquitoes and let them loose to mate with wild females. Their female offspring inherit a gene that prevents them from maturing, when they would otherwise start biting humans and spreading deadly diseases. A pilot release showed the local mosquito population was decreased by 96% over 11 months.
One hopes scientists will be cautious about employing widespread release of these males, since mosquitoes are important pollinators for thousands of plant species and serve as an important food source for birds and many aquatic species.
- https://notthebee.com/article/scientists-in-brazil-have-figured-out-a-way-to-fight-the-hoards-of-mosquitos-in-the-area-genetically-re-engineer-them-to-kill-their-own-kind
- https://www.frontiersin.org/articles/10.3389/fbioe.2022.975786/full
- https://www.britannica.com/story/what-purposes-do-mosquitoes-serve-in-ecosystems
MOVIE REVIEW: [6:25] – I haven’t see it, but Not The Bee says it’s definitely worth watching.








German Shepherd with cat toy – that is so cute. I think Daisy, our Malinois, has about half a GShep’s brain. Can’t get her to “pick up toy, put it in the toy basket” yet. But she’s good at the “turn over basket, scatter toys everywhere” part.
____
“You don’t understand anything and still trust God.” Yeah, well, I definitely don’t understand anything, but that “still trust God” part is … tough.
Right after I read today’s B&B, I clicked on a vid of a 3D model of the image on the Turin Shroud. I’ve seen this kind of thing before, so I just ffwd’d to the reveal.
I had to stop right there. Broke down weeping.
That happens sometimes when I’m confronted by the Majesty of his death.
LikeLiked by 1 person
Our Daisey is either dumb or lazy. Maybe both. Poodles are supposed to be clever and love to learn tricks. Daisey loves to beg for treats, take walks, get treats, bark at rude dogs who dare to walk past HER house (all on leashes), and stare at rude humans who haven’t finished their plates and put them on the floor yet. 🙂
LikeLike